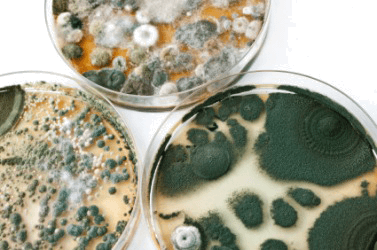

- overcasting什么意思翻译
- overcautious什么意思翻译
- overcautiously什么意思翻译
- overcautiousness什么意思翻译
- overcharge什么意思翻译
- overclass什么意思翻译
- overcloud什么意思翻译
- overcoat什么意思翻译
- overcoating什么意思翻译
- overcome什么意思翻译
- overcommit什么意思翻译
- overcommitment什么意思翻译
- overcompensate什么意思翻译
- overcompensation什么意思翻译
- overcompensatory什么意思翻译
- overconfidence什么意思翻译
- overconfident什么意思翻译
- overconfidently什么意思翻译
- overcorrect什么意思翻译
- overcorrection什么意思翻译
- overcritical什么意思翻译
- overcritically什么意思翻译
- overcrop什么意思翻译
- overcrowd什么意思翻译
- overdevelop什么意思翻译
- overdevelopment什么意思翻译
- overdo什么意思翻译
- overdoer什么意思翻译
- overdog什么意思翻译
- overdominance什么意思翻译